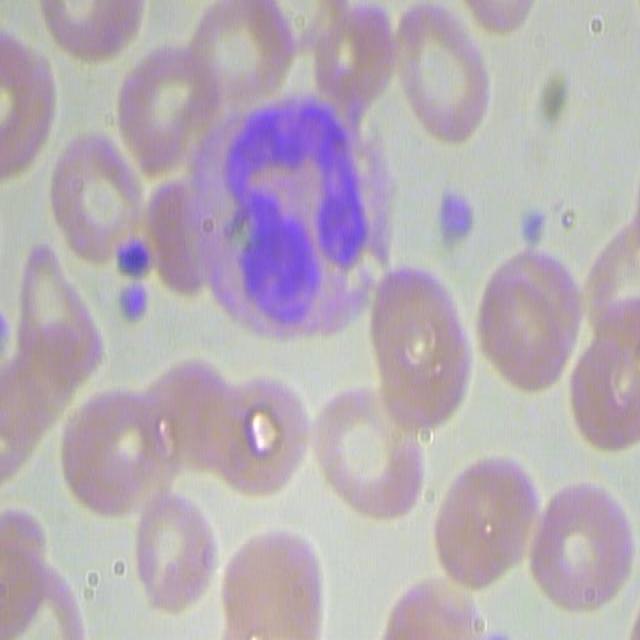
Imagen Original 3
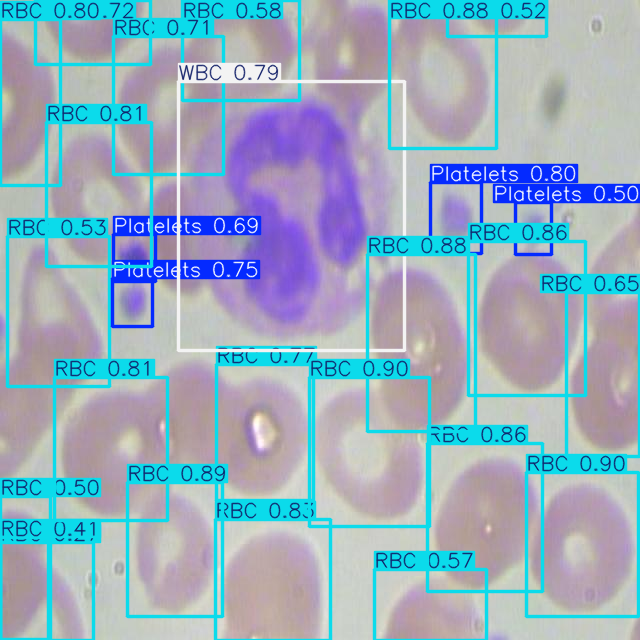
Imagen Analizada 3

MicroOV es una herramienta digital innovadora, impulsada por inteligencia artificial, diseñada para transformar la microscopía tradicional.
Esta potente herramienta será implementada en un software versátil, permitiendo realizar inferencias en vivo directamente desde el microscopio.
Imagine la capacidad de analizar en tiempo real células sanguíneas, sedimentos urinarios y muchas otras muestras microscópicas, obteniendo resultados precisos y automatizados al instante. MicroOV está llevando la inteligencia artificial al laboratorio.
Innovando en la automatización de laboratorios.
Implementación de algoritmos avanzados para el análisis microscópico.
Soluciones para digitalizar y automatizar flujos de trabajo en laboratorios.
Accede a tus datos y análisis desde cualquier lugar de forma segura.
Arrastra el deslizador para comparar la imagen original con el análisis de IA.